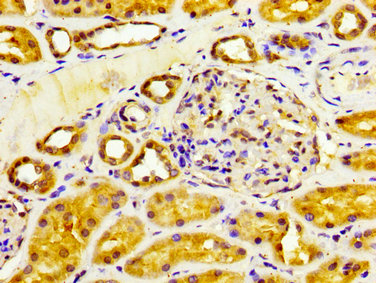

CYP4F2 Antibody
-
中文名稱:CYP4F2兔多克隆抗體
-
貨號:CSB-PA006451LA01HU
-
規格:¥440
-
圖片:
-
IHC image of CSB-PA006451LA01HU diluted at 1:200 and staining in paraffin-embedded human kidney tissue performed on a Leica BondTM system. After dewaxing and hydration, antigen retrieval was mediated by high pressure in a citrate buffer (pH 6.0). Section was blocked with 10% normal goat serum 30min at RT. Then primary antibody (1% BSA) was incubated at 4°C overnight. The primary is detected by a biotinylated secondary antibody and visualized using an HRP conjugated SP system.
-
-
其他:
產品詳情
-
產品名稱:Rabbit anti-Homo sapiens (Human) CYP4F2 Polyclonal antibody
-
Uniprot No.:
-
基因名:CYP4F2
-
別名:CYP4F2Cytochrome P450 4F2 antibody; EC 1.14.14.1 antibody; 20-hydroxyeicosatetraenoic acid synthase antibody; 20-HETE synthase antibody; Arachidonic acid omega-hydroxylase antibody; CYPIVF2 antibody; Cytochrome P450-LTB-omega antibody; Docosahexaenoic acid omega-hydroxylase antibody; EC 1.14.14.79 antibody; Leukotriene-B(4) 20-monooxygenase 1 antibody; Leukotriene-B(4) omega-hydroxylase 1 antibody; EC 1.14.14.94 antibody; Phylloquinone omega-hydroxylase CYP4F2 antibody; EC 1.14.14.78 antibody
-
宿主:Rabbit
-
反應種屬:Human
-
免疫原:Recombinant Human Phylloquinone omega-hydroxylase CYP4F2 protein (268-373AA)
-
免疫原種屬:Homo sapiens (Human)
-
標記方式:Non-conjugated
本頁面中的產品,CYP4F2 Antibody (CSB-PA006451LA01HU),的標記方式是Non-conjugated。對于CYP4F2 Antibody,我們還提供其他標記。見下表:
-
克隆類型:Polyclonal
-
抗體亞型:IgG
-
純化方式:>95%, Protein G purified
-
濃度:It differs from different batches. Please contact us to confirm it.
-
保存緩沖液:Preservative: 0.03% Proclin 300
Constituents: 50% Glycerol, 0.01M PBS, pH 7.4 -
產品提供形式:Liquid
-
應用范圍:ELISA, IHC
-
推薦稀釋比:
Application Recommended Dilution IHC 1:200-1:500 -
Protocols:
-
儲存條件:Upon receipt, store at -20°C or -80°C. Avoid repeated freeze.
-
貨期:Basically, we can dispatch the products out in 1-3 working days after receiving your orders. Delivery time maybe differs from different purchasing way or location, please kindly consult your local distributors for specific delivery time.
-
用途:For Research Use Only. Not for use in diagnostic or therapeutic procedures.
相關產品
靶點詳情
-
功能:A cytochrome P450 monooxygenase involved in the metabolism of various endogenous substrates, including fatty acids, eicosanoids and vitamins. Mechanistically, uses molecular oxygen inserting one oxygen atom into a substrate, and reducing the second into a water molecule, with two electrons provided by NADPH via cytochrome P450 reductase (CPR; NADPH-ferrihemoprotein reductase). Catalyzes predominantly the oxidation of the terminal carbon (omega-oxidation) of long- and very long-chain fatty acids. Displays high omega-hydroxylase activity toward polyunsaturated fatty acids (PUFAs). Participates in the conversion of arachidonic acid to omega-hydroxyeicosatetraenoic acid (20-HETE), a signaling molecule acting both as vasoconstrictive and natriuretic with overall effect on arterial blood pressure. Plays a role in the oxidative inactivation of eicosanoids, including both proinflammatory and anti-inflammatory mediators such as leukotriene B4 (LTB4), lipoxin A4 (LXA4), and several HETEs. Catalyzes omega-hydroxylation of 3-hydroxy fatty acids. Converts monoepoxides of linoleic acid leukotoxin and isoleukotoxin to omega-hydroxylated metabolites. Contributes to the degradation of very long-chain fatty acids (VLCFAs) by catalyzing successive omega-oxidations and chain shortening. Plays an important role in vitamin metabolism by chain shortening. Catalyzes omega-hydroxylation of the phytyl chain of tocopherols (forms of vitamin E), with preference for gamma-tocopherols over alpha-tocopherols, thus promoting retention of alpha-tocopherols in tissues. Omega-hydroxylates and inactivates phylloquinone (vitamin K1), and menaquinone-4 (MK-4, a form of vitamin K2), both acting as cofactors in blood coagulation.
-
基因功能參考文獻:
- Epistatic interactions associated with susceptibility to coronary artery disease were found between rs9332978 of CYP4A11 and rs1558139 of CYP4F2. PMID: 29484037
- The C/T genotype of the CYP4AF2 rs1558139 polymorphism might serve as a protective factor for male patients with hypertension in Asian populations, and CYP4AF2 rs2108622 may confer reduced genetic susceptibility to coronary heart disease. PMID: 29426278
- Data suggests that expression of CYP4F2 is down-regulated in liver of mice with non-alcoholic fatty liver disease after high-fat/Western diet and in human hepatocyte cell line exposed to excess palmitic acid, oleic acid, or fructose. Two other genes are down-regulated, PPAR gamma and SREBP-1. (PPAR = peroxisome proliferator-activated receptor; SREBP-1 = sterol regulatory element-binding protein-1) PMID: 28628909
- show that children on chronic warfarin therapy have low levels of vitamin K and vitamin K levels are linked to CYP4F2 genotype PMID: 28521079
- impact of CYP4F2, ABCB1, and GGCX polymorphisms on bleeding episodes associated with acenocoumarol in Russian patients with atrial fibrillation PMID: 27662649
- CYP4F2 gene repression and a sustained vitamin E metabolism appear to be independent effects of ethanol toxicity in human hepatocytes PMID: 28062356
- CYP4A1l rs9333025 GG and CYP4F2 rs2108622 GG two-loci interaction significantly increases the risk for IS and an elevated 20-HETE level. PMID: 26959478
- This study provides data on VKORC1 and CYP4F2 variants among an indigenous Ghanaian population. PMID: 27938396
- This meta-analysis indicated the impact of the CYP4F2 polymorphism on bleeding complications and over-anticoagulation in coumarin-treated patients failed to reach the level of statistical significance. PMID: 27052278
- Did not find any association of the CYP4F2 gene rs2108622 polymorphism with hypertension. PMID: 26634476
- Study showed that the V433M polymorphism in CYP4F2, responsible for epoxyeicosatrienoic acids synthesis, was an independent risk factor for post-transplant diabetes mellitus. PMID: 26483195
- Bearing of two minor alleles of CYP4F2 missense variant modestly explains inter-ethnic differences of studied populations. CYP4F2*3 risk allele frequency of Roma was in higher range, and of Hungarians in lower range, compared with other world populations PMID: 26176903
- CYP4F2 c.1297A polymorphism has a moderate effect on VKAs dose requirements in Slavic population from Central-Eastern Europe. PMID: 25042728
- The frequency of CYP2C9, CYP4F2, and VKORC1 polymorphisms in Russian patients with thrombosis is comparable with other European ethnic groups. PMID: 24858991
- To evaluate the associations between four single-nucleotide polymorphisms (SNPs) in CYP4A11 and CYP4F2 and ischemic stroke (IS) PMID: 25734770
- Plasma VK1 and MK-4 concentrations are influenced by CYP4F2 genetic polymorphism but not associated with warfarin therapy in Japanese patients. CYP4F2 polymorphism is poorly associated with inter-individual variability of warfarin dosage requirement. PMID: 25747538
- CYP4F2 gene polymorphism might increase the risk of ischemic stroke in the Chinese population. PMID: 25730002
- Around 42.5% of the overall interindividual variability in warfarin dose requirements was explained : VKORC1 genotype accounted for 29.6%, CYP2C9 genotype for 4.3%, age for 3.6%, the CYP4F2 genotype for 3.3%, and CAR/HNF4alpha (rs2501873/rs3212198) for 1.7% PMID: 25356900
- Although initial studies on CYP4F2 were focused on its role as a regulator of LTB4 and 20-HETE, current investigations focus on how variants of CYP4F2 affect warfarin drug dosing and safety PMID: 25370453
- CYP2C19*2*2 versus *1*1 and *1*2 genotype (OR: 11.625; 95% CI: 3.498-38.633), CYP4F2 AA versus GA and GG genotype (OR: 3.532; 95% CI: 1.153-10.822) were associated with early stent thrombosis. PMID: 25712182
- Polymorphisms in CYP4F2 gene is associated with warfarin dose changes in different race during venous thromboembolism. PMID: 26024874
- Our study of 250 cases of major bleeding found that CYP2C9*3 (OR: 2.05, 95% CI [1.04,4.04]), but not CYP2C9*2, VKORC1 or CYP4F2, increased the risk of major bleeding PMID: 25521356
- Maintenance of lower blood pressure after weight loss is more difficult for carriers of the CYP4F2 G1347A polymorphism and may be related to increased arterial stiffness and increased 20-HETE synthesis. PMID: 24984178
- VKORC1 variant (-1639A) was shown to be prevalent amongst Tibeto-Burmans, whereas CYP2C9 (R144C, I359L) and CYP4F2 (V433M) variants were observed in considerable variability amongst Indo-Europeans PMID: 25155935
- The allele frequency for CYP4F2 1347 G>A is 43.14 in north Indians but did not have significant bearing on the maintenance dose of acenocoumarol oral anticoagulant in cardiac valve replacement patients. PMID: 24927344
- distribution of INR was influenced by variants in CYP4F2 rs2108622, CYP2C9*3, rs9332230, VKORC1 1173C>T, -1639G>A, rs55894764, ABCB1 rs2032582, rs1128503, rs1045642 and F5 rs6025, age, smoking and concomitant drugs PMID: 24911077
- In addition to VKORC1 and CYP2C9, CYP4F2 gene has a slight but significant role in reaching INR >2.5 during the first weeks of acenocoumarol therapy. PMID: 24956252
- CYP4F2 gene polymorphisms were associated with the risk of CHD in Chinese population. PMID: 24886380
- The effect of CYP2C9, VKORC1 and CYP4F2 polymorphism and of clinical factors on warfarin dosage during initiation and long-term treatment after heart valve surgery. PMID: 23677510
- CYP4F2-derived 20-HETE mediates EC proliferation. PMID: 24668751
- CYP4F2 1297T allele was associated with mild (Child-Pugh class A-B) cirrhosis. PMID: 24319743
- High CYP omega-hydroxylase expression is asosciated with pancreatic ductal adenocarcinoma. PMID: 23846787
- CYP2C9 (p=0.004) and VKORC1 (p=0.02) variant carriers required lower cumulative doses, and CYP4F2 carriers required higher doses (p=0.04) of warfarin to reach an INR of 2.0 PMID: 24029542
- The study identifies common polymorphisms limked to warfarin resistance and sensitivity in the VKORC1, CYP2C9 and CYP4F2 genes. PMID: 23726967
- CYP3A4 and CYP4F2 single nucleotide polymorphism have effects on stable phenprocoumon and acenocoumarol maintenance doses PMID: 23510058
- Microsomal menaquinone-4 omega-hydroxylation activities correlated with the CYP4F2 V433M genotype but not the CYP4F11 D446N genotype PMID: 24138531
- CYP4F2 genetic variation did not affect the pharmacokinetics and pharmacodynamics of low-dose warfarin. PMID: 22855348
- Multiple regression analysis in the Hispanic-American cohort revealed that each CYP4F2 433M allele was associated with a 22% increase in warfarin maintenance dose (p = 0.019). PMID: 23215885
- These result show that single nucleotide polymorphisms of CYP4F2 exerted no significant effects on baseline coagulation activity assessed by fully carboxylated plasma normal prothrombin (NPT) PMID: 23018470
- Functional polymorphisms in CYP2C9, CYP4F2 and VKORC1 genes affect response to warfarin dose in an admixed Omani patient cohort. PMID: 22854539
- Dose variability in CYP4F2 genotypes is attributable to both warfarin clearance and sensitivity differences in Korean patients with mechanical heart valves. PMID: 22549502
- Our results show that the CYP4F2 p.V433M polymorphism is associated with interindividual variability in response to coumarin drugs PMID: 23132553
- Found the frequency of the CYP4F2 rs2108622 C allele in individuals with implanted mechanical valve prostheses was 79.5% and T-allele frequency was 20.5%.TT-homozygous individuals required a 0.56 mg/day higher dose of warfarin than their CC counterparts. PMID: 23013706
- The multiple linear regression model including VKORC1-1639G>A, CYP2C9, CYP4F2 and clinical factors (body surface area (BSA) and age) could explain 42 % of the variance in the warfarin maintenance dose. PMID: 22528326
- Report algorithm predicting warfarin dose in Chinese Han patients with valvular atrial fibrillation based on CYP4F2/CYP2C9/VKORC1 polymorphisms. PMID: 22534826
- The initial positive association of the CYP4F2 V433M polymorphism with components of metabolic syndrome and MetS itself, found in MDC-CVA, was partially denied in another large cohort. PMID: 22484021
- The present study indicated that VKORC1, CYP4F2, and CYP2C9 genotypes and interacting drugs had a significant impact on the warfarin maintenance dose in Chinese patients with heart valve replacement PMID: 22198820
- The researchers evaluated the prevalence of the CYP4F2 polymorphism in a population of Omanis. PMID: 22452429
- Quantitative PCR assays for VKORC1, CYP4F2, GGCX and CALU identified two copies in all populations. PMID: 22188360
- Impact of genetic factors (VKORC1, CYP2C9, CYP4F2 and EPHX1) on the anticoagulation response to fluindione PMID: 21883387
顯示更多
收起更多
-
相關疾病:Coumarin resistance (CMRES)
-
亞細胞定位:Microsome membrane; Peripheral membrane protein. Endoplasmic reticulum membrane; Peripheral membrane protein.
-
蛋白家族:Cytochrome P450 family
-
組織特異性:Liver. Also present in kidney: specifically expressed in the S2 and S3 segments of proximal tubules in cortex and outer medulla.
-
數據庫鏈接:
Most popular with customers
-
YWHAB Recombinant Monoclonal Antibody
Applications: ELISA, WB, IHC, IF, FC
Species Reactivity: Human, Mouse, Rat
-
Phospho-YAP1 (S127) Recombinant Monoclonal Antibody
Applications: ELISA, WB, IHC
Species Reactivity: Human
-
-
-
-
-
-